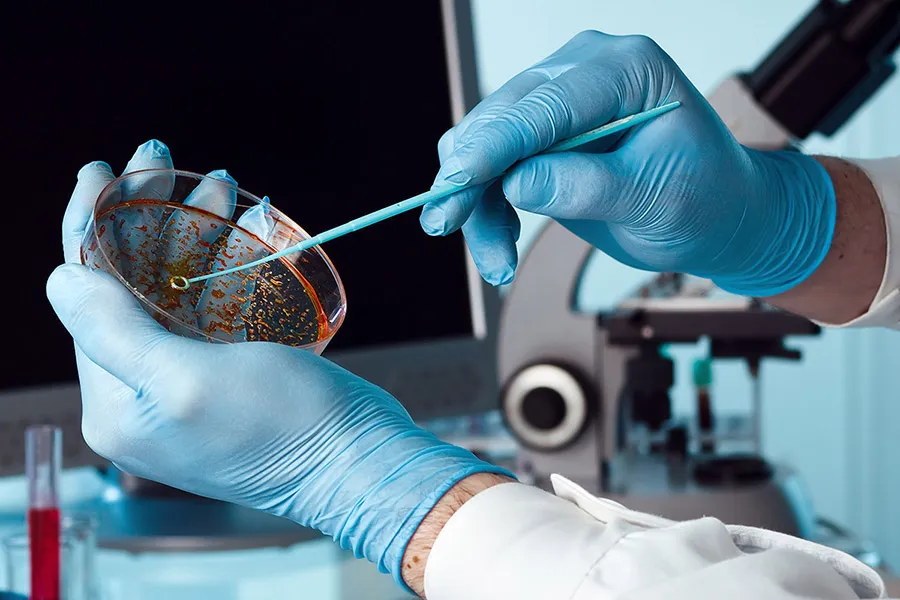

Magíster en Sistemas de Gestión Integral de la Calidad UFRO recibe acreditación por seis años

Este magíster, adscrito al Departamento de Ingeniería Industrial y de Sistemas de la Facultad de Ingeniería y Ciencias de la Universidad de La Frontera (UFRO), fue acreditado por un periodo de seis años por la Comisión Nacional de Acreditación (CNA), siendo, hasta la fecha, el único programa de esta especialidad acreditado a nivel nacional.
Estudiantes son beneficiarios de beca otorgada por Magíster en Administración de Empresas UFRO

Damari Flores Jiménez de la carrera de Contador Público y Auditor, Penélope Fierro Díaz de Derecho y José Jiménez Aburto de Ingeniería Comercial, son los estudiantes becarios que se encuentran actualmente cursando programa de postgrado MBA-UFRO este 2024.
Encuentro de Tutoras/es Pares UFRO reúne a estudiantes y profesionales de la Red de Acompañamiento Académico Estudiantil

Este encuentro se focalizó en socializar y compartir las buenas prácticas tutoriales de los diversos programas de acompañamiento de nuestra Universidad.
Más de cien estudiantes de La Araucania son premiados en XVII Campeonato de Matemática UFRO

Estudiantes entre cuarto básico y cuarto medio de diferentes establecimientos educacionales de la región y país fueron premiados en la XVII versión del Campeonato de Matemática, organizado por el Centro de Apoyo Matemático y Vinculación Temprana (CAMVIT) del Departamento de Matemática y Estadística de la Universidad de La Frontera (UFRO).
Académico UFRO es uno de los ganadores de la convocatoria “Explora” realizada por holding nacional de alimentos
Propuesta del Dr. Andrés Santos Ñanculef fue uno de los siete proyectos seleccionados en la versión 2024 de la iniciativa organizada por HUBTEC Chile, con apoyo de SOFOFA Hub y TransferenciAP.